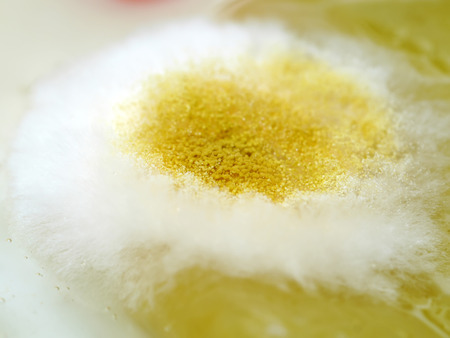
Yellow Mold on the food. (Rhizopus stolonifer)の写真素材

写真素材 - Yellow Mold on the food. (Rhizopus stolonifer)
キーワード
- bread
- close
- closeup
- conidia
- contaminated
- decay
- food
- fungal
- fungus
- harmful
- hypha
- hyphae
- inedible
- infected
- loaf
- macro
- magnification
- microorganism
- mildew
- mildewed
- mold
- moldiness
- moldy
- musty
- perishable
- poisonous
- rhizopus
- rotten
- rotting
- slice
- spoiled
- spore
- stolonifer
- toxic
- unedible
- unhealthy
- unhygienic
- unpalatable
- unpleasant
- up
- background
類似作品
Backgrounds of ...
a rotten lemon ...
Yellow fungus ...
mold in orange ...
Yellow fungus ...
Aspergillus (mo...
Close-up of mol...
Single whole ye...
Extreme close-u...
Blue-green mold...
Backgrounds of ...
Moldy bread or ...
yellow mold spo...
Mold on semolin...
Mold grown at o...
Tiny Slime mold...
Penicillium, as...
photo of fungi ...
Backgrounds Col...
mold on a lemon...
Blurred backgro...
Mold. Nice mold...
Backgrounds of ...
Closeup on deco...
Extreme close-u...
Green mold on f...
Tiny Slime mold...
Mold growing ra...
Backgrounds of ...
yellow mold bac...
Tiny Slime mold...
Microscopic vie...
Bread mold. Bea...
Fungus caused b...
Backgrounds Col...
Backgrounds of ...
Rhizopus (bread...
the green mold ...
Close-up of gre...
Aspergillus (mo...
photo of fungi ...
Aspergillus (mo...
Backgrounds Col...
Close up of mol...
Colony of paras...
Closeup of Mold...
spread of green...
Rot and mold on...
Shot of mold on...